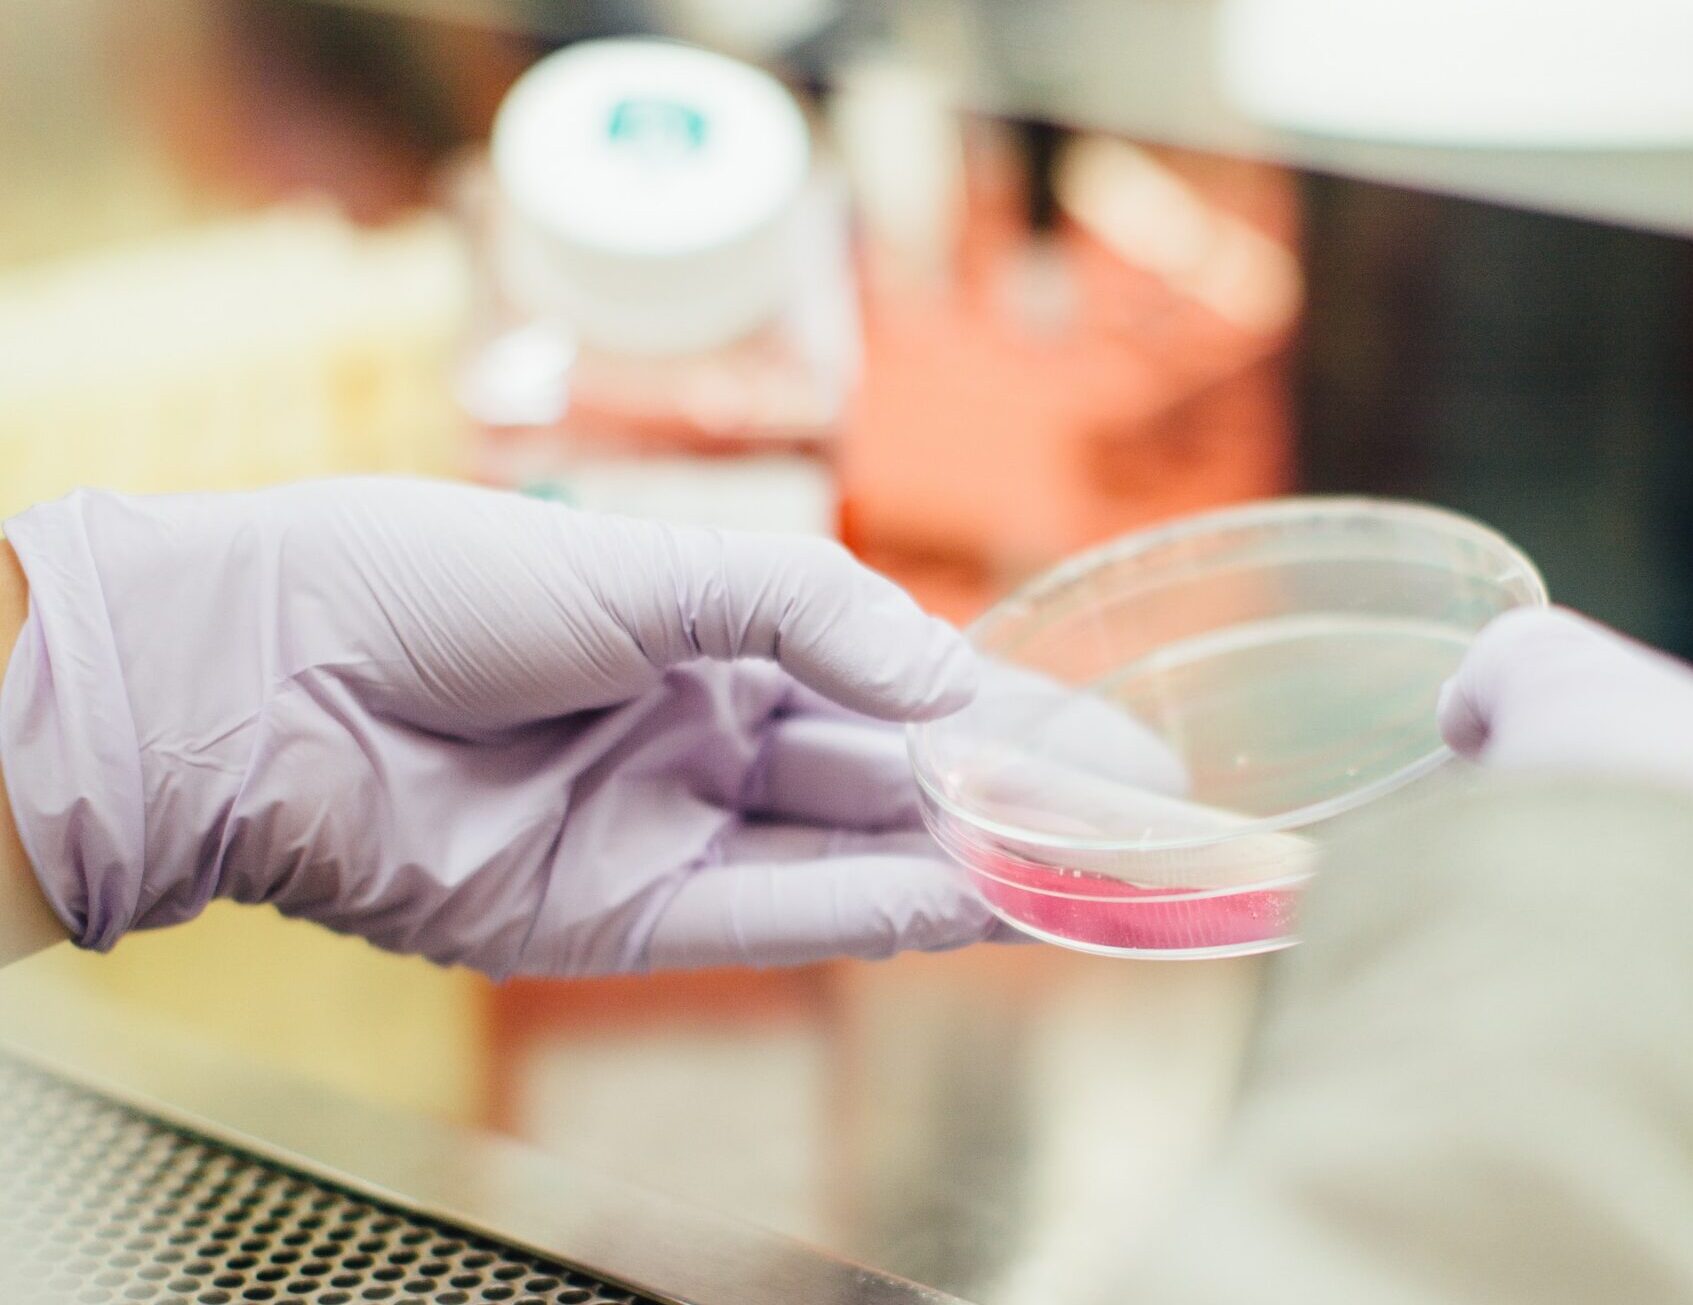
Debatte um Laborfleisch in Österreich: Parteien im Dialog über die Zukunft der Lebensmittelproduktion

In Österreichs Konsumentenschutzausschuss wurden mehrere Anträge der Oppositionsparteien, die sich unter anderem mit Themen wie Bankfilialerreichbarkeit, Kreditvergabe an Ältere und dem Verbot bestimmter Glücksspiele befassen, vorläufig zurückgestellt. Ein besonders kontrovers diskutiertes Thema ist das Inverkehrbringen von Laborfleisch, das unterschiedliche Reaktionen hervorruft.
ÖVP und Grüne vs. FPÖ: Positionen zum Inverkehrbringen von Laborfleisch
Die FPÖ positioniert sich deutlich gegen die Zulassung von Laborfleisch, und betont die Notwendigkeit, sowohl die Gesundheit der Konsumenten als auch österreichische Traditionen und heimische Produkte zu schützen. Peter Schmiedlechner von der FPÖ unterstreicht die Bedenken bezüglich der gesundheitlichen und konsumentenschutzrechtlichen Auswirkungen von Laborfleisch.
Laborfleisch in Österreich: Eine Debatte über die Zukunft der Ernährung
Im Gegensatz dazu argumentiert Ulrike Fischer von den Grünen, dass Laborfleisch das Potential hat, Tierleid zu minimieren, und sieht die Bedenken der FPÖ als unbegründet an. Andreas Kühberger von der ÖVP äußert allerdings Sorgen über einen möglichen höheren CO2-Ausstoß durch die Produktion von Laborfleisch im Vergleich zur herkömmlichen Tierhaltung.
Katharina Werner von den NEOS hält eine spezifisch nationale Gesetzgebung für unnötig und warnt vor Panikmache. Sie betont die sich wandelnden Ernährungsgewohnheiten, insbesondere bei der jüngeren Generation, und die Notwendigkeit für Landwirte, neue Einkommensquellen zu erschließen. Die SPÖ sieht das Thema bereits ausreichend durch die EU-Verordnung zu neuartigen Lebensmitteln (Novel Food) geregelt.
Gesundheit, Tradition und Umwelt: Die Kernpunkte der Laborfleisch-Diskussion
Diese Debatte spiegelt die unterschiedlichen Perspektiven und Herausforderungen wider, die mit der Einführung von Laborfleisch verbunden sind. Während einige Parteien die Vorteile hinsichtlich Tierwohl und Nachhaltigkeit hervorheben, betonen andere die Bedeutung von Tradition, Gesundheitsschutz und Umweltauswirkungen. Die Zukunft der Lebensmittelproduktion in Österreich bleibt ein aktuelles und viel diskutiertes Thema.

